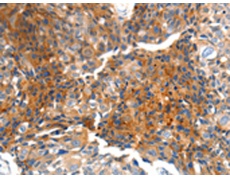
一抗

中文名稱: 兔抗MTNR1A多克隆抗體
英文名稱: Anti-MTNR1A rabbit polyclonal antibody
別 名: MT1, MEL-1A-R
相關(guān)類別: 一抗
儲(chǔ) 存: 冷凍(-20℃)
宿 主: Rabbit
抗 原: MTNR1A
反應(yīng)種屬: Human, Mouse, Rat
標(biāo) 記 物: Unconjugate
克隆類型: rabbit polyclonal
技術(shù)規(guī)格
|
Background: |
This gene encodes one of two high affinity forms of a receptor for melatonin, the primary hormone secreted by the pineal gland. This receptor is a G-protein coupled, 7-transmembrane receptor that is responsible for melatonin effects on mammalian circadian rhythm and reproductive alterations affected by day length. The receptor is an integral membrane protein that is readily detectable and localized to two specific regions of the brain. The hypothalamic suprachiasmatic nucleus appears to be involved in circadian rhythm while the hypophysial pars tuberalis may be responsible for the reproductive effects of melatonin. |
|
Applications: |
ELISA, WB, IHC |
|
Name of antibody: |
MTNR1A |
|
Immunogen: |
Synthetic peptide of human MTNR1A |
|
Full name: |
melatonin receptor 1A |
|
Synonyms: |
MT1, MEL-1A-R |
|
SwissProt: |
P48039 |
|
ELISA Recommended dilution: |
1000-5000 |
|
IHC positive control: |
Human breast cancer |
|
IHC Recommend dilution: |
100-300 |
|
WB Predicted band size: |
39 kDa |
|
WB Positive control: |
NIH/3T3 cells |
|
WB Recommended dilution: |
1000-3000 |


 購(gòu)物車
購(gòu)物車 幫助
幫助
 021-54845833/15800441009
021-54845833/15800441009